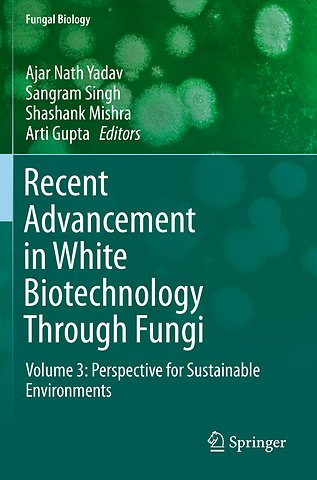
Recent Advancement in White Biotechnology Through Fungi

Recent Advancement in White Biotechnology Through Fungi
Volume 3: Perspective for Sustainable Environments
Samenvatting
Over the last decade considerable progress has been made in white biotechnology research and further major scientific and technological breakthroughs are expected in the future. The first large-scale industrial applications of modern biotechnology have been in the areas of food and animal feed production (agricultural/green biotechnology) and in pharmaceuticals (medical/red biotechnology). In contrast, the productions of bioactive compounds through fermentation or enzymatic conversion are known as industrial or white biotchnology. The fungi are ubiquitous in nature and have been sorted out from different habitats, including extreme environments (high temperature, low temperature, salinity and pH); and associated with plants (Epiphytic, Endophytic and Rhizospheric).
The fungal strains are beneficial as well as harmful for human beings. The beneficial fungal strains may play important roles in the agricultural, industrial, and medical sectors. The fungal strains and its product (enzymes, bioactive compounds, and secondary metabolites) are very useful for industry (e.g., the discovery of penicillin from Penicillium chrysogenum). This discovery was a milestone in the development of white biotechnology as the industrial production of penicillin and antibiotics using fungi moved industrial biotechnology into the modern era, transforming it into a global industrial technology. Since then, white biotechnology has steadily developed and now plays a key role in several industrial sectors providing both high value nutraceutical and pharmaceutical products. The fungal strains and bioactive compounds also play an important role in environmental cleaning. This volume covers the latest research developments related to value-added products in white biotechnology through fungi.
Specificaties
Inhoudsopgave
<p>Bioremediation: New Prospects for Environmental Cleaning by Fungal Enzymes</p>
<p>Dr. Neha Vishnoi, Babasaheb Bhimrao Ambedkar University, India</p>
<p> </p>
<p>Chapter 2</p>
<p>Fungal Enzyme System for Saccharification of Lignocellulosic Feedstocks</p>
<p>Dr. Devendra Mani Tripathi, Bundelkhand University, India</p>
Chapter 3 White-Rot Fungi and Their Enzymes for the Treatment of Industrial Dye Effluents <p>Dr. P. Devagi, Tamil Nadu Agriculture University, Coimbatore, India</p>
<p> </p>
<p>Chapter 4</p>
<p>Fungal Secretomes: Biodegradation Lignocelluloses and Biopolymers</p>
Dr. Nasib Singh, Eternal University, Baru Sahib, India<p></p>
<p> </p>
<p>Chapter 5</p>
<p>Fungal Enzymes for Bioremediation of Xenobiotic Compounds</p>
<p>Dr. Rajinikanth Mohan, Colgate University, NY</p>
<p> </p>
<p>Chapter 6</p>
<p>Pleurotus ostreatus: a Biofactory for Lignin Degrading Enzymes of Diverse Industrial Applications</p>
Dr. Hesham El Enshasy, Universiti Teknologi Malaysia (UTM), Johor Bahru, Malaysia<p></p>
<p> </p>
<p>Chapter 7</p>
<p>Extracellular Fungal Peroxidases and Laccases for Waste Treatment: Recent Improvement</p>
<p>Dr. N. Sivakumar, Madurai Kamaraj University, Madurai, India</p>
<p> </p>
<p>Chapter 8</p>
<p>Fungal Enzymes for Bioremediation of Contaminated Soil</p>
Dr. Prem Chandra, Baba Saheb Bhimrao Ambedkar (A Central) University, India<p></p>
<p> </p>
<p>Chapter 9</p>
<p>Fungal Enzymes for Bio conversion of Lignocellulosic Biomass</p>
<p>Dr Yogeshvari K. Jhala, Department of Microbiology, AAU, India</p>
<p></p>
<p>Chapter 10</p>
<p>Industrially Important Pigments from Different Groups of Fungi</p>
<p>Dr. Ashok Kumar, RGSC, Banaras Hindu University, India</p>
<p> </p>
<p>Chapter 11</p>
<p>Bioconversion of Biomass to Biofuel using Fungal Consortium</p>
<p>Dr. Ch. Pavana Jyothi, GITAM University, Visakhapatnam, India</p>
Chapter 12 Bioremediation of polycyclic aromatic hydrocarbons (PAHs) contaminated soil through fungal community <p>Dr. Elisabet Aranda, Institute for Water Research, University of Granada, Granada, Spain</p>
<p> </p>
<p> </p>
<p>Chapter 13</p>
<p>Role of Fungi in Climate Change Abatement and Nitrogen Supplement</p>
<p>Dr. Sandeep K. Malyan,CESCRA, IARI, ND-12, India</p>
<p> </p>
<p>Chapter 14</p>
<p>Fungal-Phytoremediation of heavy metal contaminated land and water resources: Current Scenario and Future Prospects</p>
<p>Dr. Amit Kumar, FIAES, Dayalbagh Educational Institute, Agra, India</p>
<p> </p>
<p>Chapter 15</p>
<p>Biotechnological Applications of β-Glucosidases in Biomass Degradation</p>
<p>Dr. Sushma Mishra, Dayalbagh Educational Institute,India</p>
<p> </p>
<p>Chapter16</p>
<p>Genetic diversity of methylotrophic yeast and their impact to the environment</p>
<p>Dr. Manish Kumar, Amity Institute of Biotechnology (AIB), Amity University, India</p>
<p> </p>
<p>Chapter 17</p>
<p>Microbial enzymes and its Application in Pulp and Paper Industry</p>
Dr. Ashish Vyas, Lovely Professional University, Phagwara, Punjab, India<p></p>
<p> Appendixes</p><p>Index </p></div>